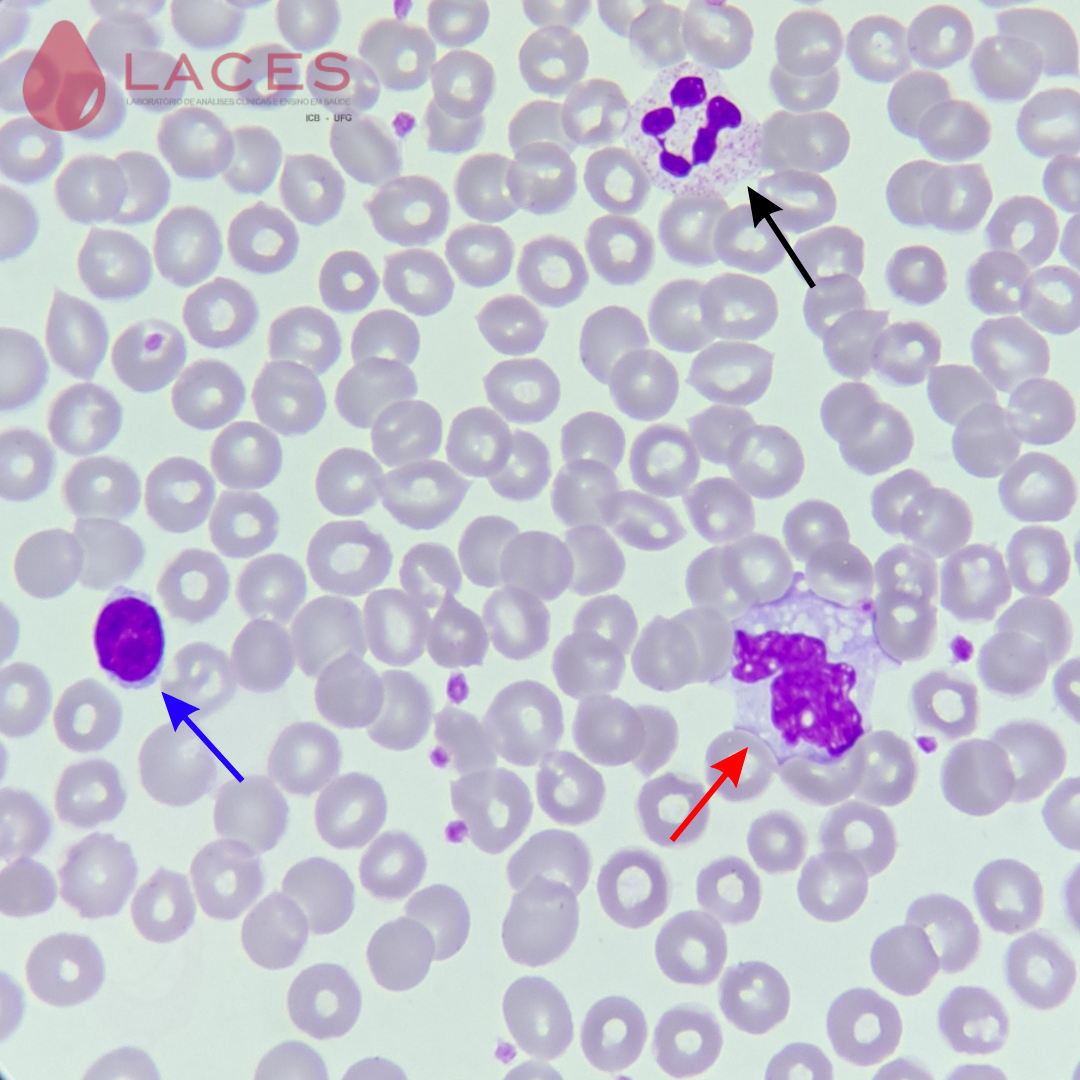
Leucócitos
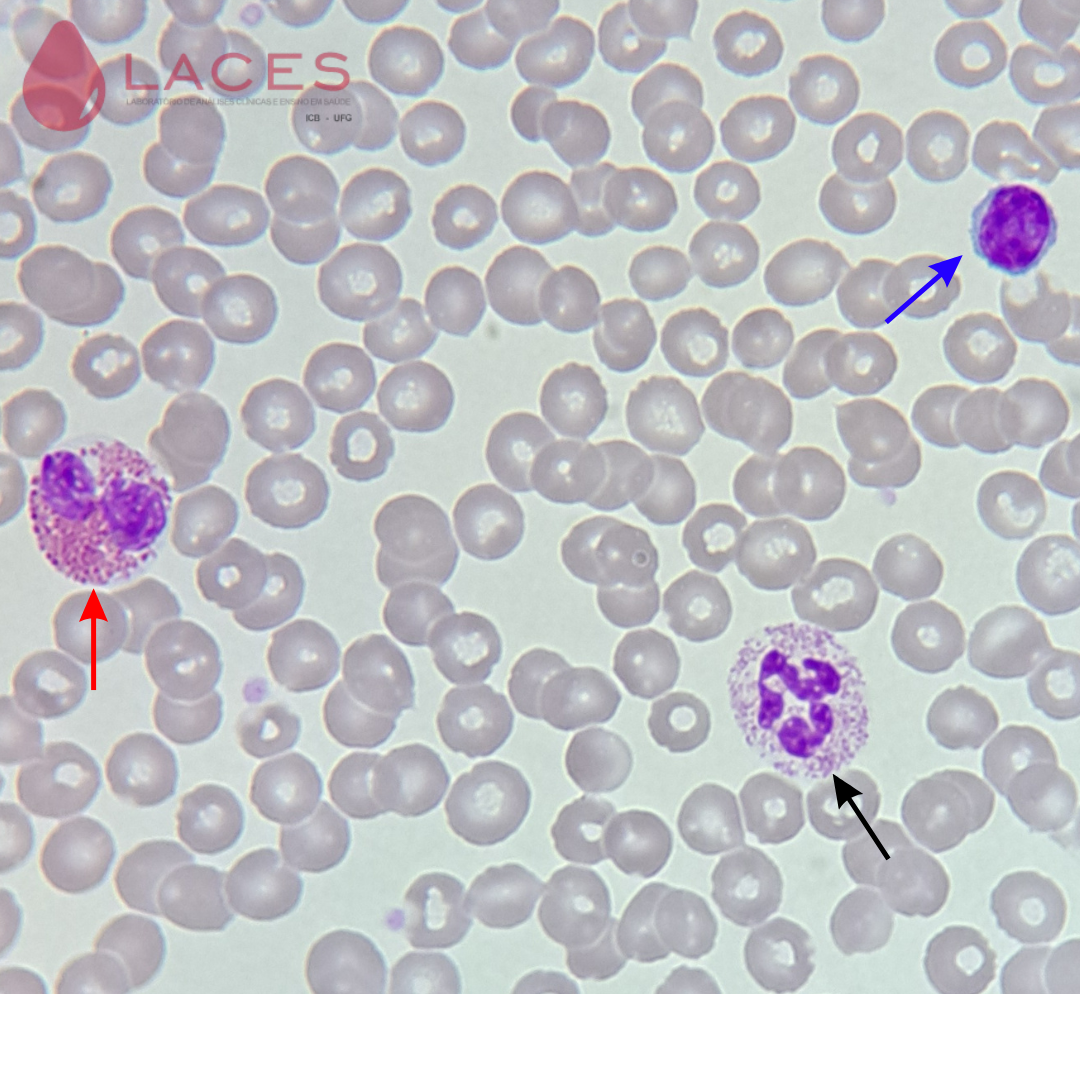
Leucócitos

Leucócitos

Figura 1: Neutrófilos segmentados (seta preta), linfócito (seta azul) e monócito (seta vermelha)
Figura 2:Neutrófilo segmentado (seta preta), monócito (seta vermelha) e linfócito (seta azul)
Figura 3 :Neutrófilo segmentado (seta preta), eosinófilo (seta vermelha) e linfócito (seta azul)
Figura 4:Neutrófilo segmentado (seta preta) e eosinófilo (seta vermelha)

Figura 5:Neutrófilo segmentado (seta preta) e eosinófilo (seta vermelha)

Figura 6: Neutrófilo Bastão ou Bastonete (seta) - neutrófilo jovem com núcleo em forma de bastão curvado.

Figura 7: Neutrófilo em bastão.
.jpg)
Figura 8: Neutrófilo segmentado (seta): neutrófilo maduro com núcleo dividido em lóbulos (2 a 5 lóbulos) e citoplasma com granulações finas. É o leucócito que se apresenta em maior quantidade no sangue (40 a 80%). Neutrófilos (bastões e segmentados) possuem propriedades de defesa contra bactérias e fungos por quimiotaxia e fagocitose.

Figura 9: Neutrófilo segmentado.

Figura 10: Neutrófilo segmentado com corpúsculo de Barr (círculo tracejado). Este corpúsculo corresponde ao cromossomo X inativo e condensado.

Figura 11: Neutrófilos segmentados.

Figura 12: Neutrófilo em transição de bastão para segmentado (seta tracejada) e neutrófilo segmentado (seta).

Figura 13: Eosinófilo. Geralmente possuem dois lóbulos e grânulos alaranjados e grosseiros no citoplasma. Aumentam muito durante processos alérgicos e doenças parasitárias, tendo sua porcentagem normal no sangue periférico de 2 a 4%.
Figura 14: Eosinófilo (formato do núcleo característico bilobulado com grânulos eosinofílicos no citoplasma). Hemácias normocíticas e normocrômicas.

Figura 15: Eosinófilo (centro). Notar a presença de 3 lóbulos.

Figura 16: Linfócito (seta): Núcleo redondo com cromatina condensada, citoplasma escasso e levemente basofílico, tamanho pouco maior do que a hemácia. Constitui de 20 a 30% dos leucócitos, aumentando muito sua quantidade em infecções virais.

Figura 17: Monócito (no centro da imagem). São as maiores células do sangue periférico, núcleo com cromatina frouxa e reticular, e com formato irregular, podendo apresentar aspecto de rim (riniforme, como nesta figura). As suas principais funções são a fagocitose e a integração da imunidade celular e humoral.

Figura 18:Monócito apresentando vacúolos citoplasmáticos

Figura 19:Monócito apresentando vacúolos citoplasmáticos

Figura 20: Monócito.

Figura 21: Monócito.

Figura 22: Monócito.

Figura 23: Monócitos.
Figura 24: Basófilo (seta): geralmente o núcleo se apresenta em dois lóbulos e é de difícil visualização pela grande quantidade de grânulos grosseiros, densos e escuros presentes no citoplasma. Participam de processos alérgicos e são os leucócitos com menor presença no sangue periférico (de 0 a 2%). Coloração em Leishman.

Figura 25: Basófilo.

Figura 26: Monócito (seta) e Linfócito (seta tracejada).

Figura 27:Neutrófilo segmentado (seta) e Basófilo (seta tracejada).

Figura 28: Eosinófilos (setas) e Neutrófilo segmentado (seta tracejada).
